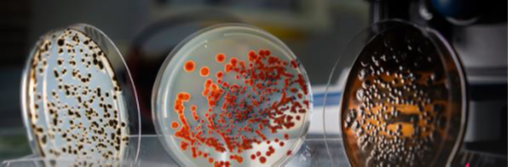

Микробные консорциумы для освоения экстремальных субстратов
Область применения:
Биоремедиация бедных микробиотой почв, восстановление плодородия после техногенного воздействия, биоинженерия безжизненных субстратов в экстремальных условиях и внеземной среде.
Ключевые характеристики:
- Количество штаммов: 10
- Устойчивость к радиации, в 200+ раз превышающей земной фон, на 30% выше, чем на МКС.
Описание результата: Коллектив молодежной лаборатории разработал микробный консорциум из десяти штаммов, специально подобранных для функционирования в экстремальных условиях.
Консорциум включает штаммы почвенных бактерий и грибов из Ростовской области. Цианобактерии осуществляют фотосинтез, актиномицеты и бациллы обеспечивают синтез биоактивных соединений и гумуса, отдельные штаммы обеспечивают устойчивость к окислительному стрессу и засухе.
В сотрудничестве с Институтом медико-биологических проблем (ИМБП) РАН консорциум был успешно запущен на орбиту на борту научного космического аппарата «Бион-М» № 2 и вернулся на Землю в отличном состоянии (18 октября 2025). Все микроорганизмы успешно пережили экстремальные условия космического полета. В наземных испытаниях консорциум демонстрирует эффективность в искусственном «марсианском» реголите, создавая среду для роста тестовой культуры — ячменя.